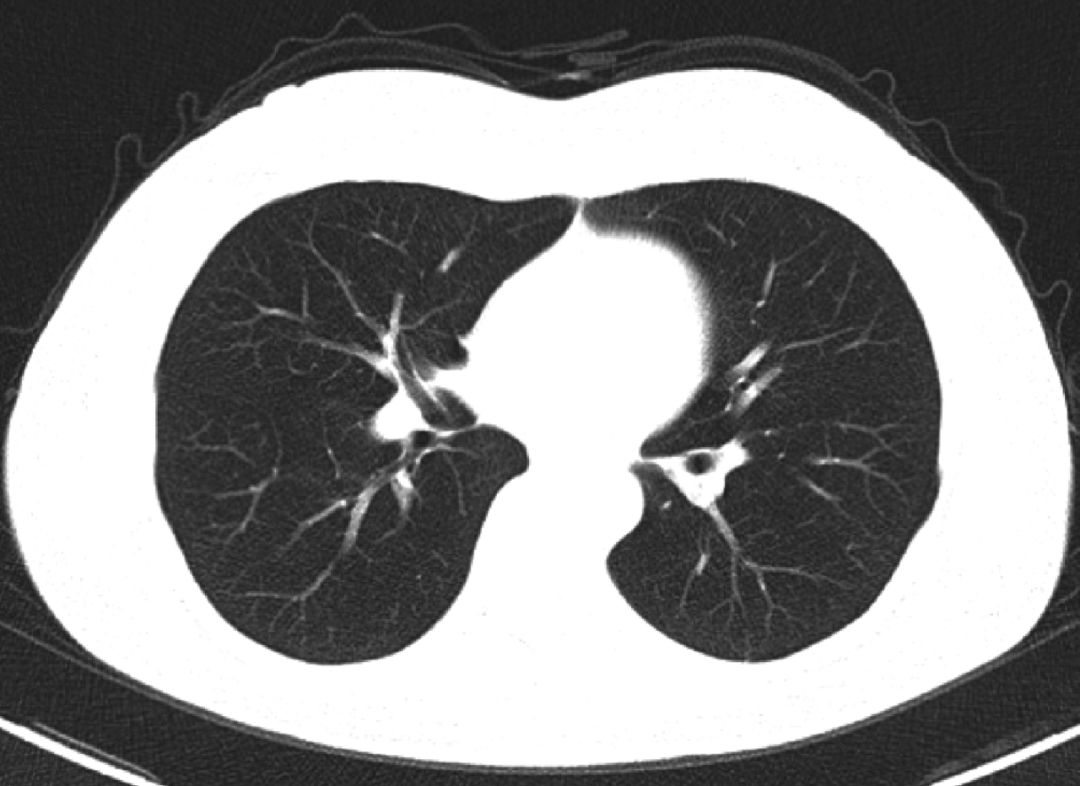
分子靶向治疗和基因靶向治疗,分子靶向治疗视频

恶性肿瘤始终是威胁人类生命的疾病之一。尽管科技在发展,医学诊疗技术和手段在不断更新,医疗工作者对抗疾病的“工具箱”装备越来越齐全,但大多数人依然“谈癌色变”。不仅仅因为癌症的致命性,还因为治疗的过程对于患者和家属都是相当痛苦的;其既消磨人的生命和意志,又让患者生活质量大打折扣,同时也摧残着整个家庭。
中国无论是癌症发病率还是死亡率都还在持续上升,防癌抗癌之路任重道远。
传统的癌症治疗方式主要以手术、放疗和化疗为主。近些年,随着分子生物学研究的进展,“新型疗法”——分子靶向治疗成为人们关注的热点。与传统的化疗药物相比,针对肿瘤的特异性靶点设计的抗肿瘤药物具有特异性强、疗效明显、对正常组织损伤少等优点。新型分子靶向药物在临床实践中取得了显著的疗效,实践已证实分子靶向治疗理论的正确性与可行性。随着“新型疗法”的普及,癌症治疗将进入“精准医疗”时代,越来越强调“个体化”和“低副作用”。
目前分子靶向治疗药物仍处于研究发展的阶段,用于临床和正在试验的药物种类繁多,国际上尚无统一的分类标准。
另外,抗肿瘤药物作为一种“精准化”的治疗药物,由于患者的个体差异,如何使用才能达到最佳疗效,还需要更加严谨科学的用药指导。

案例

1
患者基本信息
女性,47 岁,PS 评分1 分。既往体健,无家族肿瘤病史,3 年前曾行卵巢癌根治术,术后病检证实为卵巢来源子宫内膜样腺癌,无其他重大疾病史。
2
诊断及治疗经过
因“卵巢癌术后3 年余,下腹坠涨伴乏力半年余”于2016 年9 月初就诊于某三甲医院。患者于3 年前于外院行卵巢癌根治术,术后病检结果证实为卵巢来源子宫内膜样腺癌,术后予以紫杉醇+顺铂方案化疗8 个周期,化疗期间定期复查未见肿瘤复发及远处转移。近半年来,患者自觉下腹坠涨,久坐或排大便时自觉坠涨感加强就诊,胸部CT 检查未见异常(图1)。上腹部及盆腔MRI 检查(图2、图3):肝脏多发占位、腹壁异常占位及盆腔直肠区域异常占位,结合病史考虑患者为卵巢癌术后盆腔复发侵犯直肠,同时并肝脏多发转移。余影像检查无明显异常。
图1 肺部CT检查结果

图2 上腹部MRI检查结果

图3 盆腔MRI检查结果
(1) 诊断 ①卵巢癌术后;②肝脏多发占位(转移性肝癌);③盆腔异常占位(种植转移)。
(2) 治疗予紫杉醇+顺铂+贝伐单抗治疗4 个周期后,肺部CT(图4):未见转移病灶。复查肝脏及盆腔MRI(图5):肝脏S2、S6 病灶消失,S4 病灶较前明显缩小。

图4 4个周期化疗+靶向治疗后肺部CT检查结果

图5 4个周期化疗+靶向治疗后上腹部MRI检查结果
3
后续治疗前评估、治疗目标和治疗策略
(1)患者转归后期患者继续化疗+贝伐单抗治疗8 个周期后,上腹部MRI 示肝多发转移灶部分消失,部分明显缩小。因患者出现无法耐受的骨髓抑制,故停用化疗,仅用贝伐单抗单药维持治疗,目前病情评估为部分缓解(PR)。
(2) 病例特点和治疗选择的依据该患者为卵巢癌Ⅳ期,肝脏多发转移,盆腔局部复发并直肠种植,为晚期卵巢癌,结合患者既往病检为卵巢来源子宫内膜样腺癌,该亚型卵巢癌预后极差。疾病恶性程度高,以延长患者生存、改善生活质量为主要治疗目标。治疗上以全身治疗为主,辅以局部治疗。
因患者既往使用紫杉醇+顺铂方案效果确切,现可考虑沿用原化疗方案,考虑患者肿瘤负荷大,常规化疗无法控制病情,故加用贝伐单抗。后续治疗策略:继续目前化疗方案联合贝伐单抗治疗。
后期患者继续化疗+贝伐单抗治疗8 个周期后,因患者出现无法耐受的骨髓抑制,故停用化疗,仅用贝伐单抗单药维持治疗,目前病情评估为PR。

更多内容请阅读董坚主编的《肿瘤靶向治疗药物与临床应用》

扫一扫,轻松下单
《肿瘤靶向治疗药物与临床应用》分三篇。第一篇为肿瘤靶向治疗药物概述,包括肿瘤靶向治疗、靶向治疗药物分类及应用和实体肿瘤靶向药物疗效评价标准。第二篇为靶向治疗药物介绍,包括药物作用机制、药代动力学、FDA 批准适应证及中国上市应用情况、剂型规格、用法用量、禁忌、特殊人群用药和临床研究介绍,共54种药物。第三篇为案例荟萃,包括患者基本情况、辅助检查、诊断及治疗经过,后续治疗前评估、治疗目标和治疗策略;共20个案例。
《肿瘤靶向治疗药物与临床应用》可供肿瘤科医生、研究生使用。
科学出版社赛医学(sci_med)
科学出版社医药卫生分社订阅号